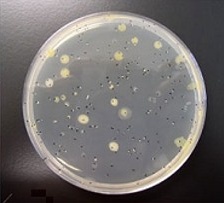
image

コロニーカウンター
コロニーカウントとは?
コロニーカウントとは?コロニーカウントは、培養によって培地上に形成されたコロニー数(CFU:Colony Forming Unit、コロニー形成単位)を計測し、サンプル中の生菌数を確認する方法です。
一般的な食品サンプルでは、培地上のコロニー数が30~300の範囲に収まる希釈倍率サンプルを採用し、そのカウント数と使用したサンプル量・希釈倍率から、1gあたりのコロニー数(CFU/g)を算出します。
コロニーカウントを行うことで、サンプル中の微生物汚染レベルを客観的に把握でき、衛生管理や品質管理の指標として活用されています。
手作業の場合
 目視で1つずつカウントしていきます。
目視で1つずつカウントしていきます。
カウントにはシャーレにカウント箇所を点字したり、手動カウンターを用いてカウント数を記録します。
自動コロニーカウンターの場合
 サンプルを台座上に置き、測定条件を選択してカウントボタンを押すだけでカウント出来ます。
サンプルを台座上に置き、測定条件を選択してカウントボタンを押すだけでカウント出来ます。
カウント時間は数秒で、培地上の実カウント数だけでなく、 1mlあたりの数も自動で算出します。
 今だからこそ、微生物検査の迅速化・省力化を図りませんか?
今だからこそ、微生物検査の迅速化・省力化を図りませんか?自動コロニーカウンターならセントラル科学貿易にお任せください!
3メーカー10モデル以上の製品をラインナップ!
コロニーカウンターの比較表がダウンロードいただける
「コロニーカウンター特設ページ」はこちらから!!
コロニーカウンターラインナップ
| 『aCOLyte3 HD エコライト3HD』 | 『Protos3 プロトス3』 | 『ProtoCOL3 プロトコル3』 |
|---|---|---|
 |
 |
 |
| コンパクト自動コロニーカウンター ▶製品ページへ |
高性能カラー識別機能付き自動コロニーカウンター ▶製品ページへ |
21CFR Part11対応 阻止円測定機能付き 自動コロニーカウンター ▶製品ページへ |
| 『スキャン500』 | 『SphereFlash スフィアフラッシュ』 | 『SphereFlash スフィアフラッシュ AI』 |
 |
 |
 |
| コロニーカウンター ▶製品ページへ |
測定チャンバー搭載型 阻止円測定・自動コロニーカウンター ▶製品ページへ |
AI機能搭載コロニーカウンター ▶製品ページへ |
| 『AutoCOL』 | 『ScanStaion』 | 『Scan50/50Pro』 |
 |
 |
 |
| 21CFR Part11対応 全自動コロニーカウンター ▶製品ページへ |
リアルタイムインキュベーター +リアルタイム自動コロニーカウンター ▶製品ページへ |
マニュアル式コロニーカウンター ▶製品ページへ |
レポート作成自動化ツール
新製品!
Synoptics社コロニーカウンター・ゾーンアナライザー用 レポート作成自動化ツール「レポートクリエーター」
お問い合わせ
フォームが表示されるまでしばらくお待ち下さい。
恐れ入りますが、しばらくお待ちいただいてもフォームが表示されない場合は、こちらまでお問い合わせください。









